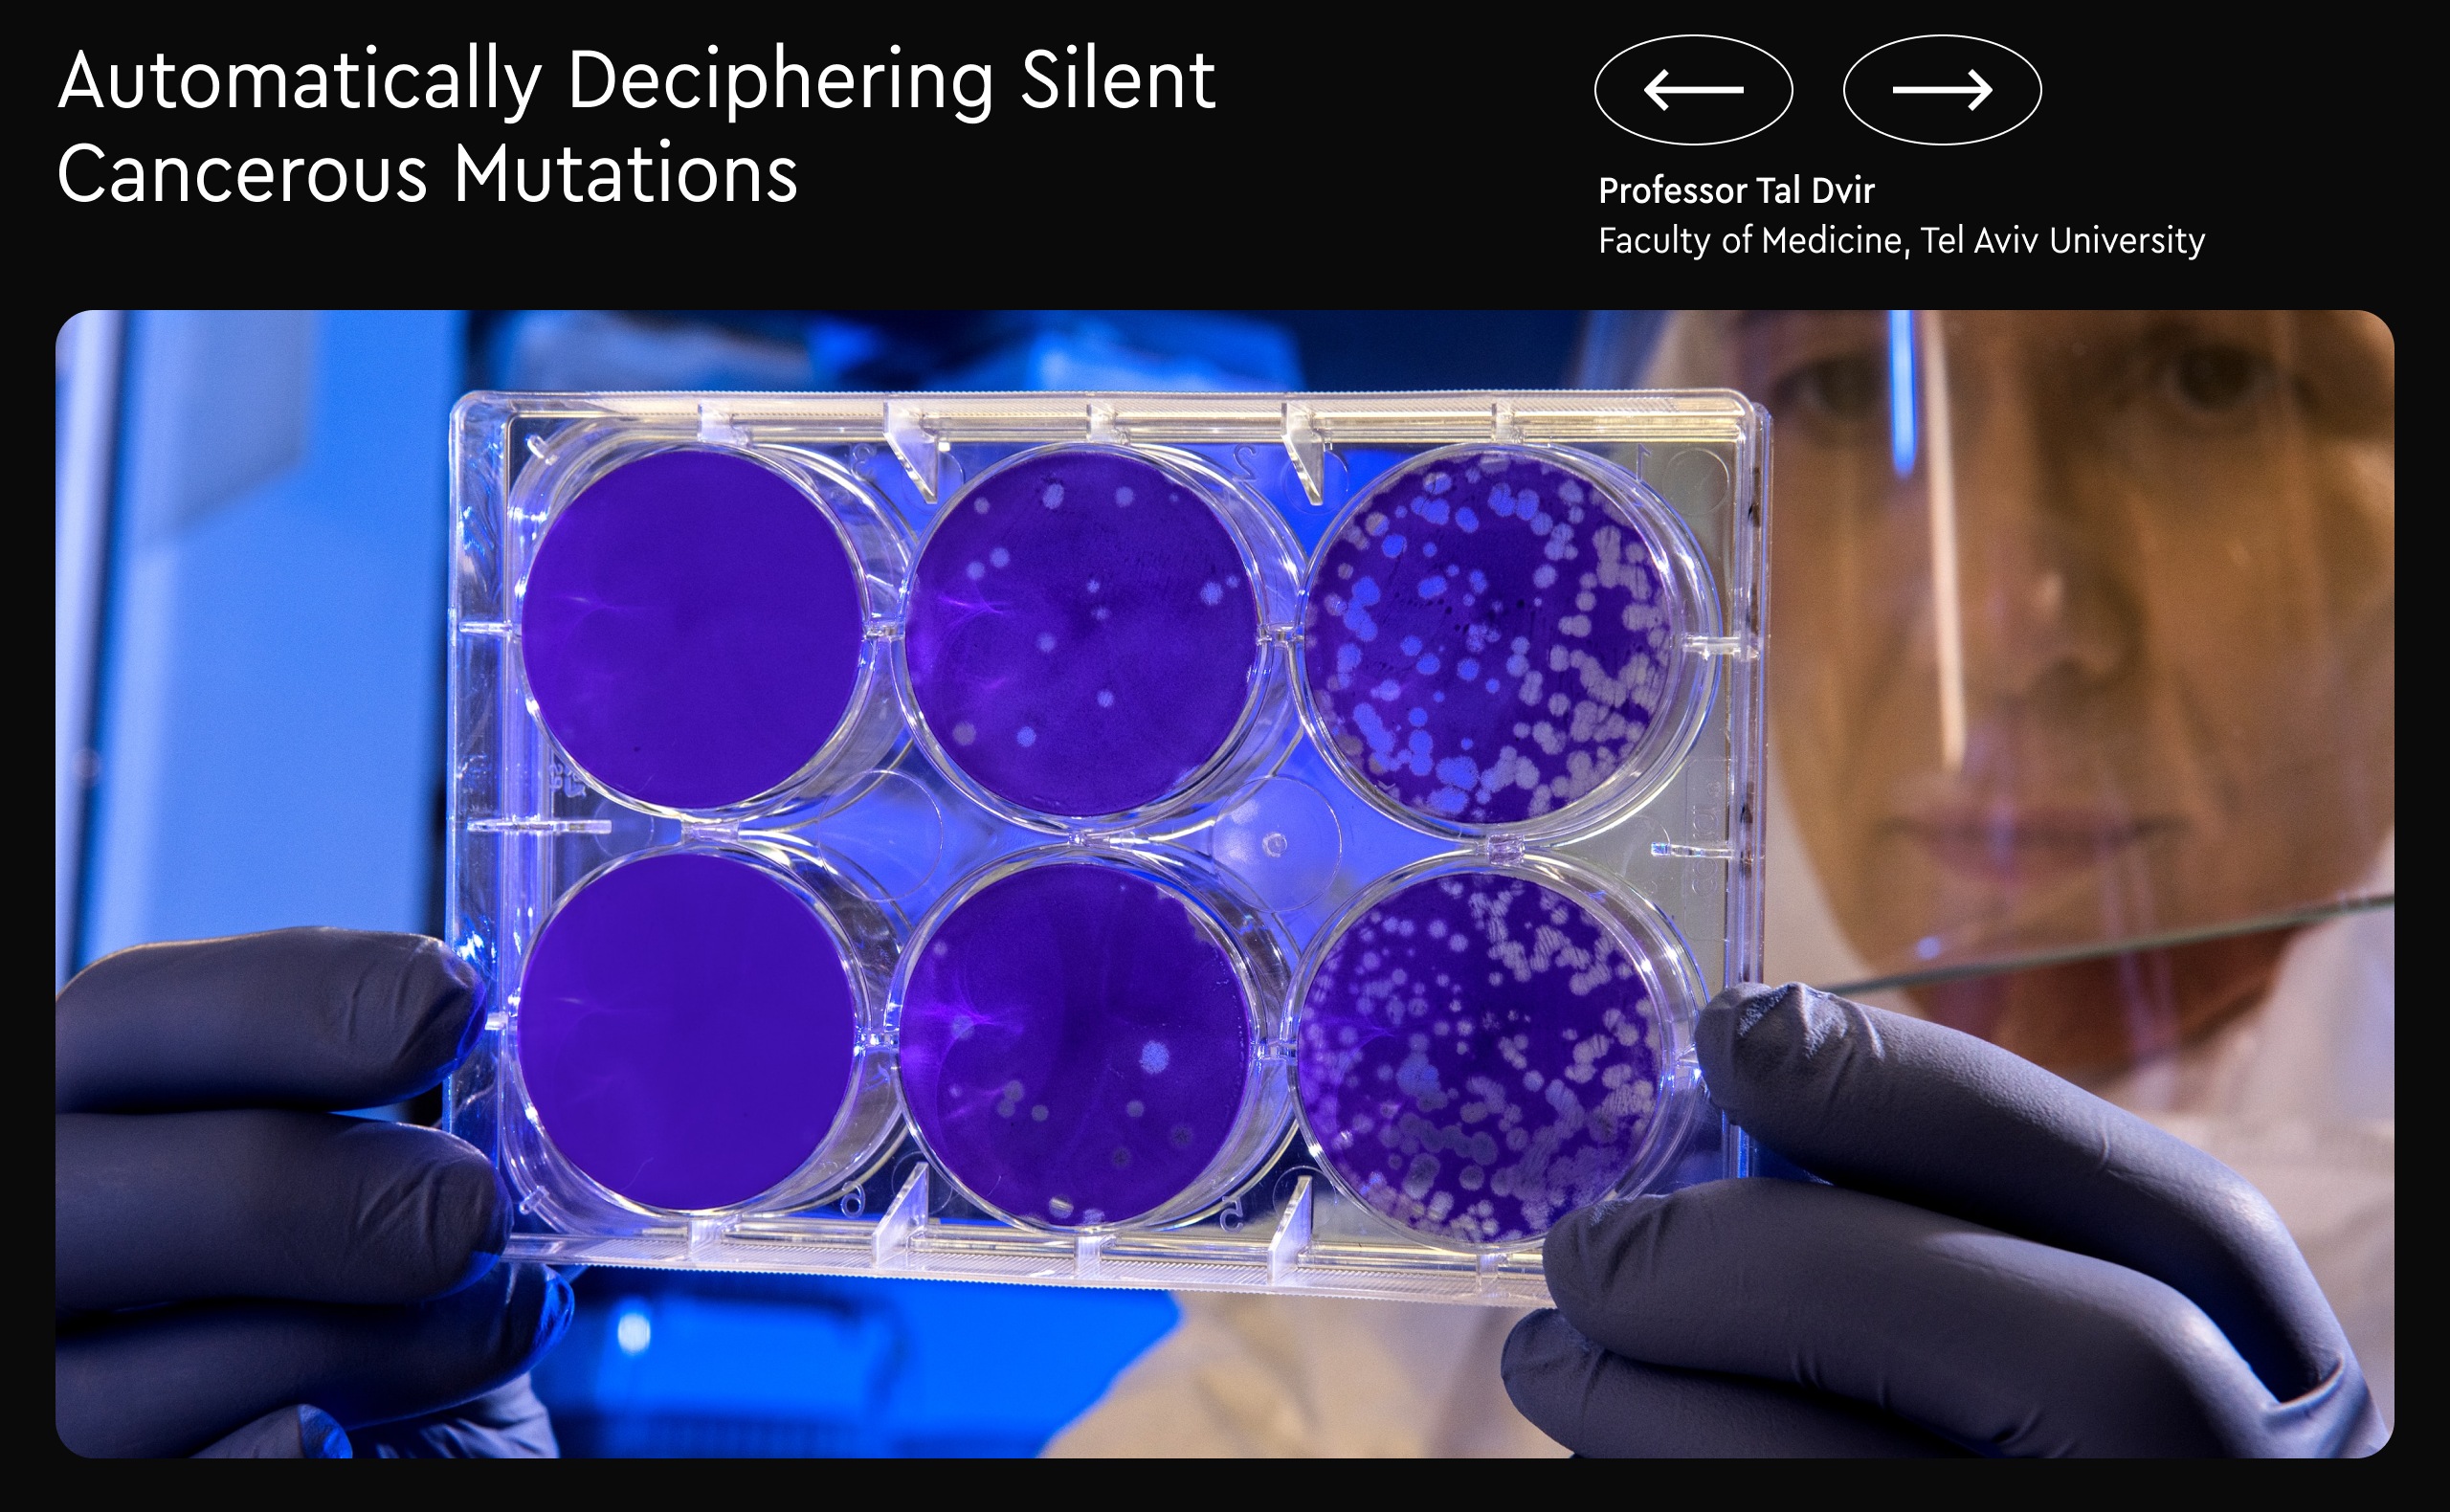

Dmitry Zimin’s Foundation “Zimin Insitutes” is engaged in philanthropic activities and opens its institutes in major foreign universities to develop projects in the fields of medicine, sociology, urban studies and human potential. The foundation supports of cancer treatment studies, 3D printing of internal organs and smart cities’ design. The studio created a website to aggregate the information about the foundation’s projects and news. The key idea of the website was waves, a metaphor for momentum and impact on human life.